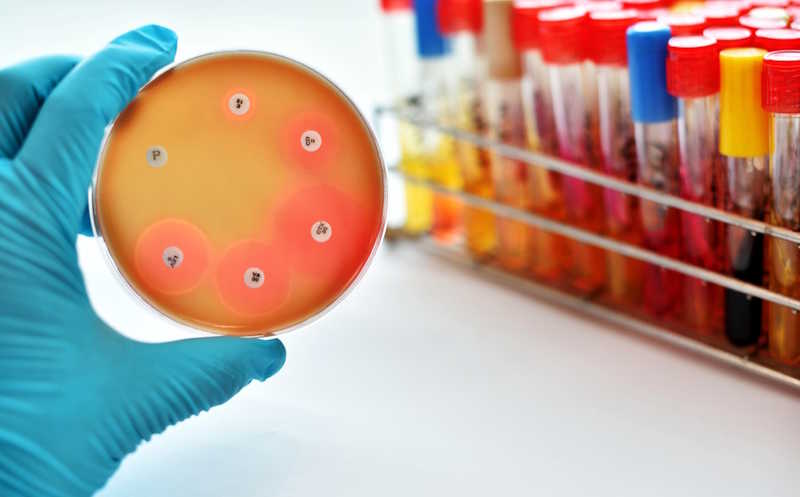

Устойчивость к антибиотикам в странах Европы выходит на плато
Антибиотикорезистентность патогенных бактерий — серьезная проблема в современном мире, и принято считать, что со временем ситуация только ухудшается. Исследование ученых из Франции и Швейцарии показало, что это не совсем так — в последние два десятилетия антибиотикорезистентность в Европе стабилизируется. Анализ динамики по 30 европейским странам показал, что только 20% траекторий устойчивости растут со временем, тогда как остальные стабильны или снижаются. Отчасти изменения объясняются тем, как меняется потребление антибиотиков, но авторы признают, что многие факторы остаются неясными.
Устойчивость бактерий к антибиотикам — одна из самых серьезных угроз для современного здравоохранения, ежегодно приводящая к миллионам смертей по всему миру. Распространено мнение, что эта проблема неуклонно усугубляется, однако масштабное исследование ученых из Швейцарии и Франции представляет неожиданные и обнадеживающие результаты. Они проанализировали динамику антибиотикорезистентности в странах Европы за два десятилетия и выяснили, что во многих случаях она не растет постоянно, а стабилизируется на определенном уровне.
Хотя устойчивость к препаратам возникает вскоре после их внедрения, ее долгосрочные тенденции до сих пор недостаточно изучены. Чтобы восполнить этот пробел, исследователи проанализировали данные о более чем 3,3 миллионах бактериальных изолятов, охватывающих 887 комбинаций «бактерия-препарат-страна» в 30 европейских странах за период 1998–2019 гг. В фокусе оказались восемь ключевых патогенов: Streptococcus pneumoniae, Staphylococcus aureus, Escherichia coli, Klebsiella pneumoniae, Enterococcus faecalis, Enterococcus faecium, Pseudomonas aeruginosa и Acinetobacter spp. Параллельно оценивалось потребление различных классов антибиотиков в стационарах и при амбулаторном лечении.
Для анализа временных трендов устойчивости были применены три модели: логистическая (предполагающая непрерывный рост), модель с выходом на плато и модель постоянного уровня. Сравнивая эти модели, авторы классифицировали динамику устойчивости как растущую, стабилизирующуюся, стабильную или снижающуюся.
Результаты показали следующее. Вопреки распространенному мнению, существенная часть (37%) проанализированных траекторий устойчивости классифицировалась как «стабильные», то есть не показывающие ни значительного роста, ни снижения. Еще 21% траекторий авторы отнесли к «стабилизирующимся» — они демонстрировали замедление роста и выход на устойчивое плато. Доля действительно растущих траекторий составила лишь 20%, а снижающихся — 21%. Это означает, что почти 60% случаев не демонстрировали устойчивого роста антибиотикорезистентности на протяжении двух десятилетий. Примечательно, что многие траектории, которые при первичном анализе казались растущими, при более детальном моделировании оказались стабилизирующимися. Особенно заметной такая переклассификация была у E. coli.
Связь между потреблением антибиотиков и устойчивостью к ним подтвердилась: в странах с широким применением антибиотиков уровни устойчивости в целом были выше, а также быстрее росли. Однако эта зависимость объясняет лишь часть вариаций — существенную роль, по-видимому, играют дополнительные факторы: генетические особенности патогенов, структура популяций, контакты между странами и сопутствующая резистентность.
Анализ показал, что динамика устойчивости сильнее коррелирует с потреблением антибиотиков в стационарах, чем в амбулаторной практике. Выявленные в больницах тренды применения не только оказались теснее связаны с флуктуациями резистентности, но и лучше соответствовали типу траектории (рост, спад и т. д.). Кроме того, схожая динамика устойчивости к одному и тому же препарату у разных видов может указывать на общие источники давления — например, внутрибольничное применение определенных антибиотиков.
Таким образом, исследование демонстрирует: несмотря на начальный рост, антибиотикорезистентность часто стабилизируется и не продолжает расти бесконечно. Это означает, что контроль применения антибиотиков может стать эффективной стратегией сдерживания резистентности. Предложенная модель с выходом на плато дает возможность точнее отслеживать и интерпретировать новые случаи устойчивости, хотя для полноценного понимания необходимо учитывать более широкий комплекс факторов, включая молекулярные и эпидемиологические данные.
Какие антибиотики снижают риск развития резистентности
Источник
Emons, M. Blanquart, F., Lehtinen, Sl. The evolution of antibiotic resistance in Europe, 1998–2019. // PLOS Pathogens 21(4), e1012945 (2025). DOI: 10.1371/journal.ppat.1012945


 Меню
Меню





 Все темы
Все темы




 0
0











